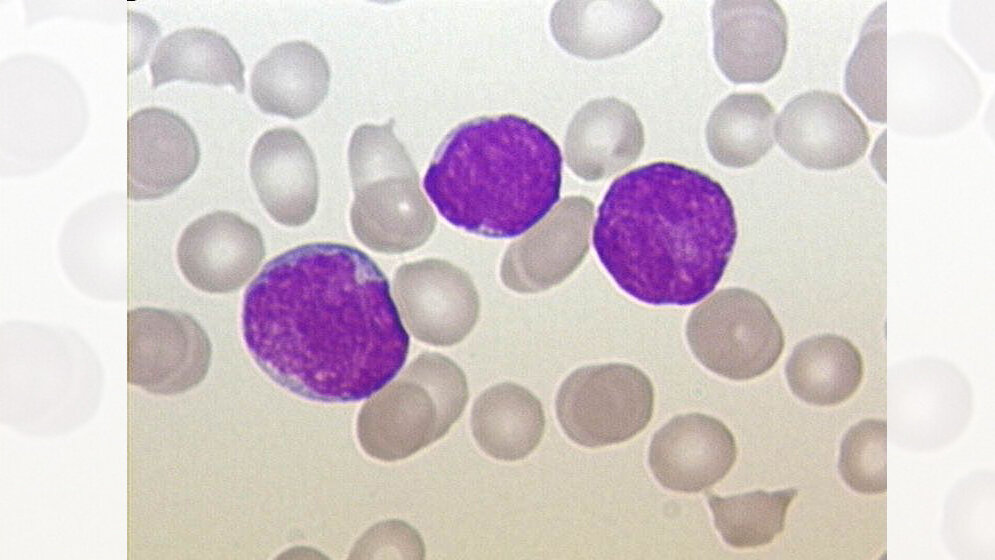
Blutausstrich eines Patienten mit ALL

Erstmalig findet eine Immuntherapie Eingang in die Erstbehandlung der ALL – potentiell kann sie mittelfristig die teils sehr toxische Chemotherapie ergänzen oder sogar ersetzen. Diese große Behandlungsstudie wurde in Deutschland am 15. Juli 2018 gestartet, in weiteren sieben Ländern im Laufe der nächsten Monate.
Leukämiekontrolle verbessern?
„Der Ersatz von Elementen der hochintensiven Chemotherapie durch eine Immuntherapie könnte Kinder vor Schaden bewahren und dabei möglicherweise sogar die Leukämiekontrolle verbessern“, sagt der Leiter der Therapiestudie, Prof. Dr. Martin Schrappe, Professor an der Christian-Albrechts-Universität zu Kiel und Direktor der Klinik für Kinder- und Jugendmedizin I des Universitätsklinikums Schleswig-Holstein (UKSH), Campus Kiel. Insgesamt erkranken jährlich ca. 600 Säuglinge, Kinder und Jugendliche bis 18 Jahren an dieser Form der Leukämie. Die ALL-Berlin-Frankfurt-Münster (BFM)-Studiengruppe unter Leitung von Prof. Schrappe ist federführend in einem der weltweit größten Konsortien zur Behandlung der ALL im Kindesalter; die erzielten Fortschritte in Diagnostik, Überwachung und Therapie sind international hochgeachtet. Allerdings ist in den vergangenen Jahren klar geworden, dass allein mit den bisher verwendeten Medikamenten eine weitere deutliche Verbesserung der ca. 80-prozentigen Heilungsrate nicht möglich sein wird. Daher sind neue Therapieformen notwendig.
Andere Nebenwirkungen möglich
Die internationale Studiengruppe, die aus 120 Kliniken in acht Ländern besteht und vom ALL-BFM-Studienzentrum an der Klinik für Kinder- und Jugendmedizin I am UKSH, Campus Kiel, aus koordiniert wird, will deshalb neue Wege gehen: Erstens werden neu entdeckte Risikogruppen gezielt einer anderen Behandlung zugeführt; zweitens werden ca. 70 Prozent der Patienten mit einem neuartigen Medikament behandelt, welches das körpereigene Immunsystem aktiviert und direkt auf die Leukämiezellen lenkt. Diese neue Therapie wurde bisher nur bei Rückfall-Patienten eingesetzt und scheint enormes Potential zu besitzen. Allerdings kann auch diese Immuntherapie starke Nebenwirkungen hervorrufen, die anders sind als die, die von der Chemotherapie bekannt sind (Haarausfall, Übelkeit, Schleimhautentzündungen, etc.). „Wir müssen bei einigen Patienten mit hohem Fieber, neurologischen Symptomen und anderen vorübergehenden Organbeeinträchtigungen rechnen“, sagt Prof. Schrappe. „Dafür gibt es aber gut etablierte Vorsichts- und Behandlungsmaßnahmen, für die bereits alle beteiligten Kliniken trainiert wurden.“ Außerdem will die Studiengruppe begleitend untersuchen, warum einige Patienten möglicherweise besonders gut und andere eher nur gering ansprechen werden.
Weitere neue Behandlung geprüft
Neben der Immuntherapie wird bei Patienten mit schlechtem Therapieansprechen eine weitere, für die Behandlung der ALL ebenfalls neuartige Therapie geprüft, bei der gezielt die Maschinerie in den Leukämiezellen blockiert wird, die die nicht mehr benötigten Zellbestandteile abbaut – in der Folge gehen die bösartigen Zellen damit an ihren eigenen Abfällen zugrunde.
Unterstützt wird das Vorhaben durch eine Förderung der Deutschen Krebshilfe, die für dieses Projekt über vier Millionen Euro zur Verfügung stellt.
Quelle: Universitätsklinikum Schleswig-Holstein
Artikel teilen